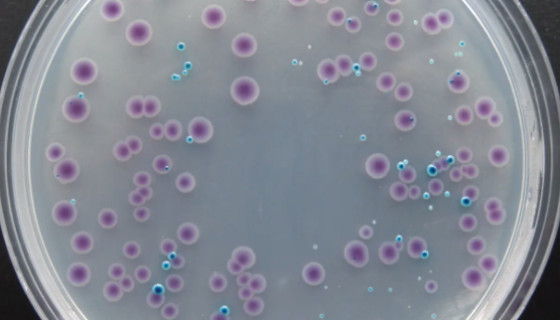
大肠杆菌显色培养基接种的操作步骤及应用！
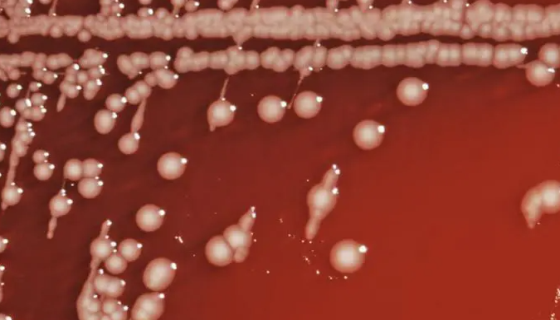
乙型副伤寒沙门氏菌的主要价值与培养方法！
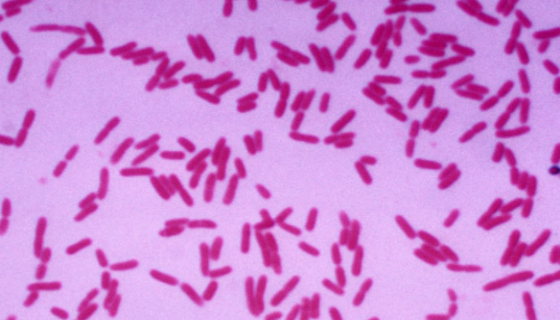
沼泽红假单胞菌的特点与功效及主要用途！

葡萄牙棒孢酵母的培养条件与注意事项及保藏方法!
葡萄牙棒孢酵母是Clavispora属的微生物,原产地为中国...

P388小鼠白血病细胞的处理方法与培养步骤!
P388小鼠白血病细胞来源于ATCC细胞库是经永生化处理的小...

霉菌斜面转接培养的实验原理与操作步骤!
霉菌斜面转接培养的实验原理与操作步骤及注意事项有哪些?

铜绿假单胞菌的性质与用途及生产工艺!
铜绿假单胞菌(P.Aeruginosa)原称绿脓杆菌。是假单...
大肠杆菌显色培养基接种的操作步骤及应用!
大肠杆菌显色培养基用于大肠杆菌的分离鉴定和计数,组分(g/L...

阿氏丝孢酵母的培养方法与注意事项及打管说明!
阿氏丝孢酵母是Trichosporon属的微生物,原产地为中...
乙型副伤寒沙门氏菌的主要价值与培养方法!
乙型副伤寒沙门氏菌是Salmonella属的微生物,原产地为...

绵羊肺成纤维细胞的处理方法与培养步骤!
绵羊肺成纤维细胞来源于一雌性绵羊的肺组织。仅用于科学研究或者...
沼泽红假单胞菌的特点与功效及主要用途!
沼泽红假单胞菌属于光合细菌(英文缩写PSB)的一种,是地球上...